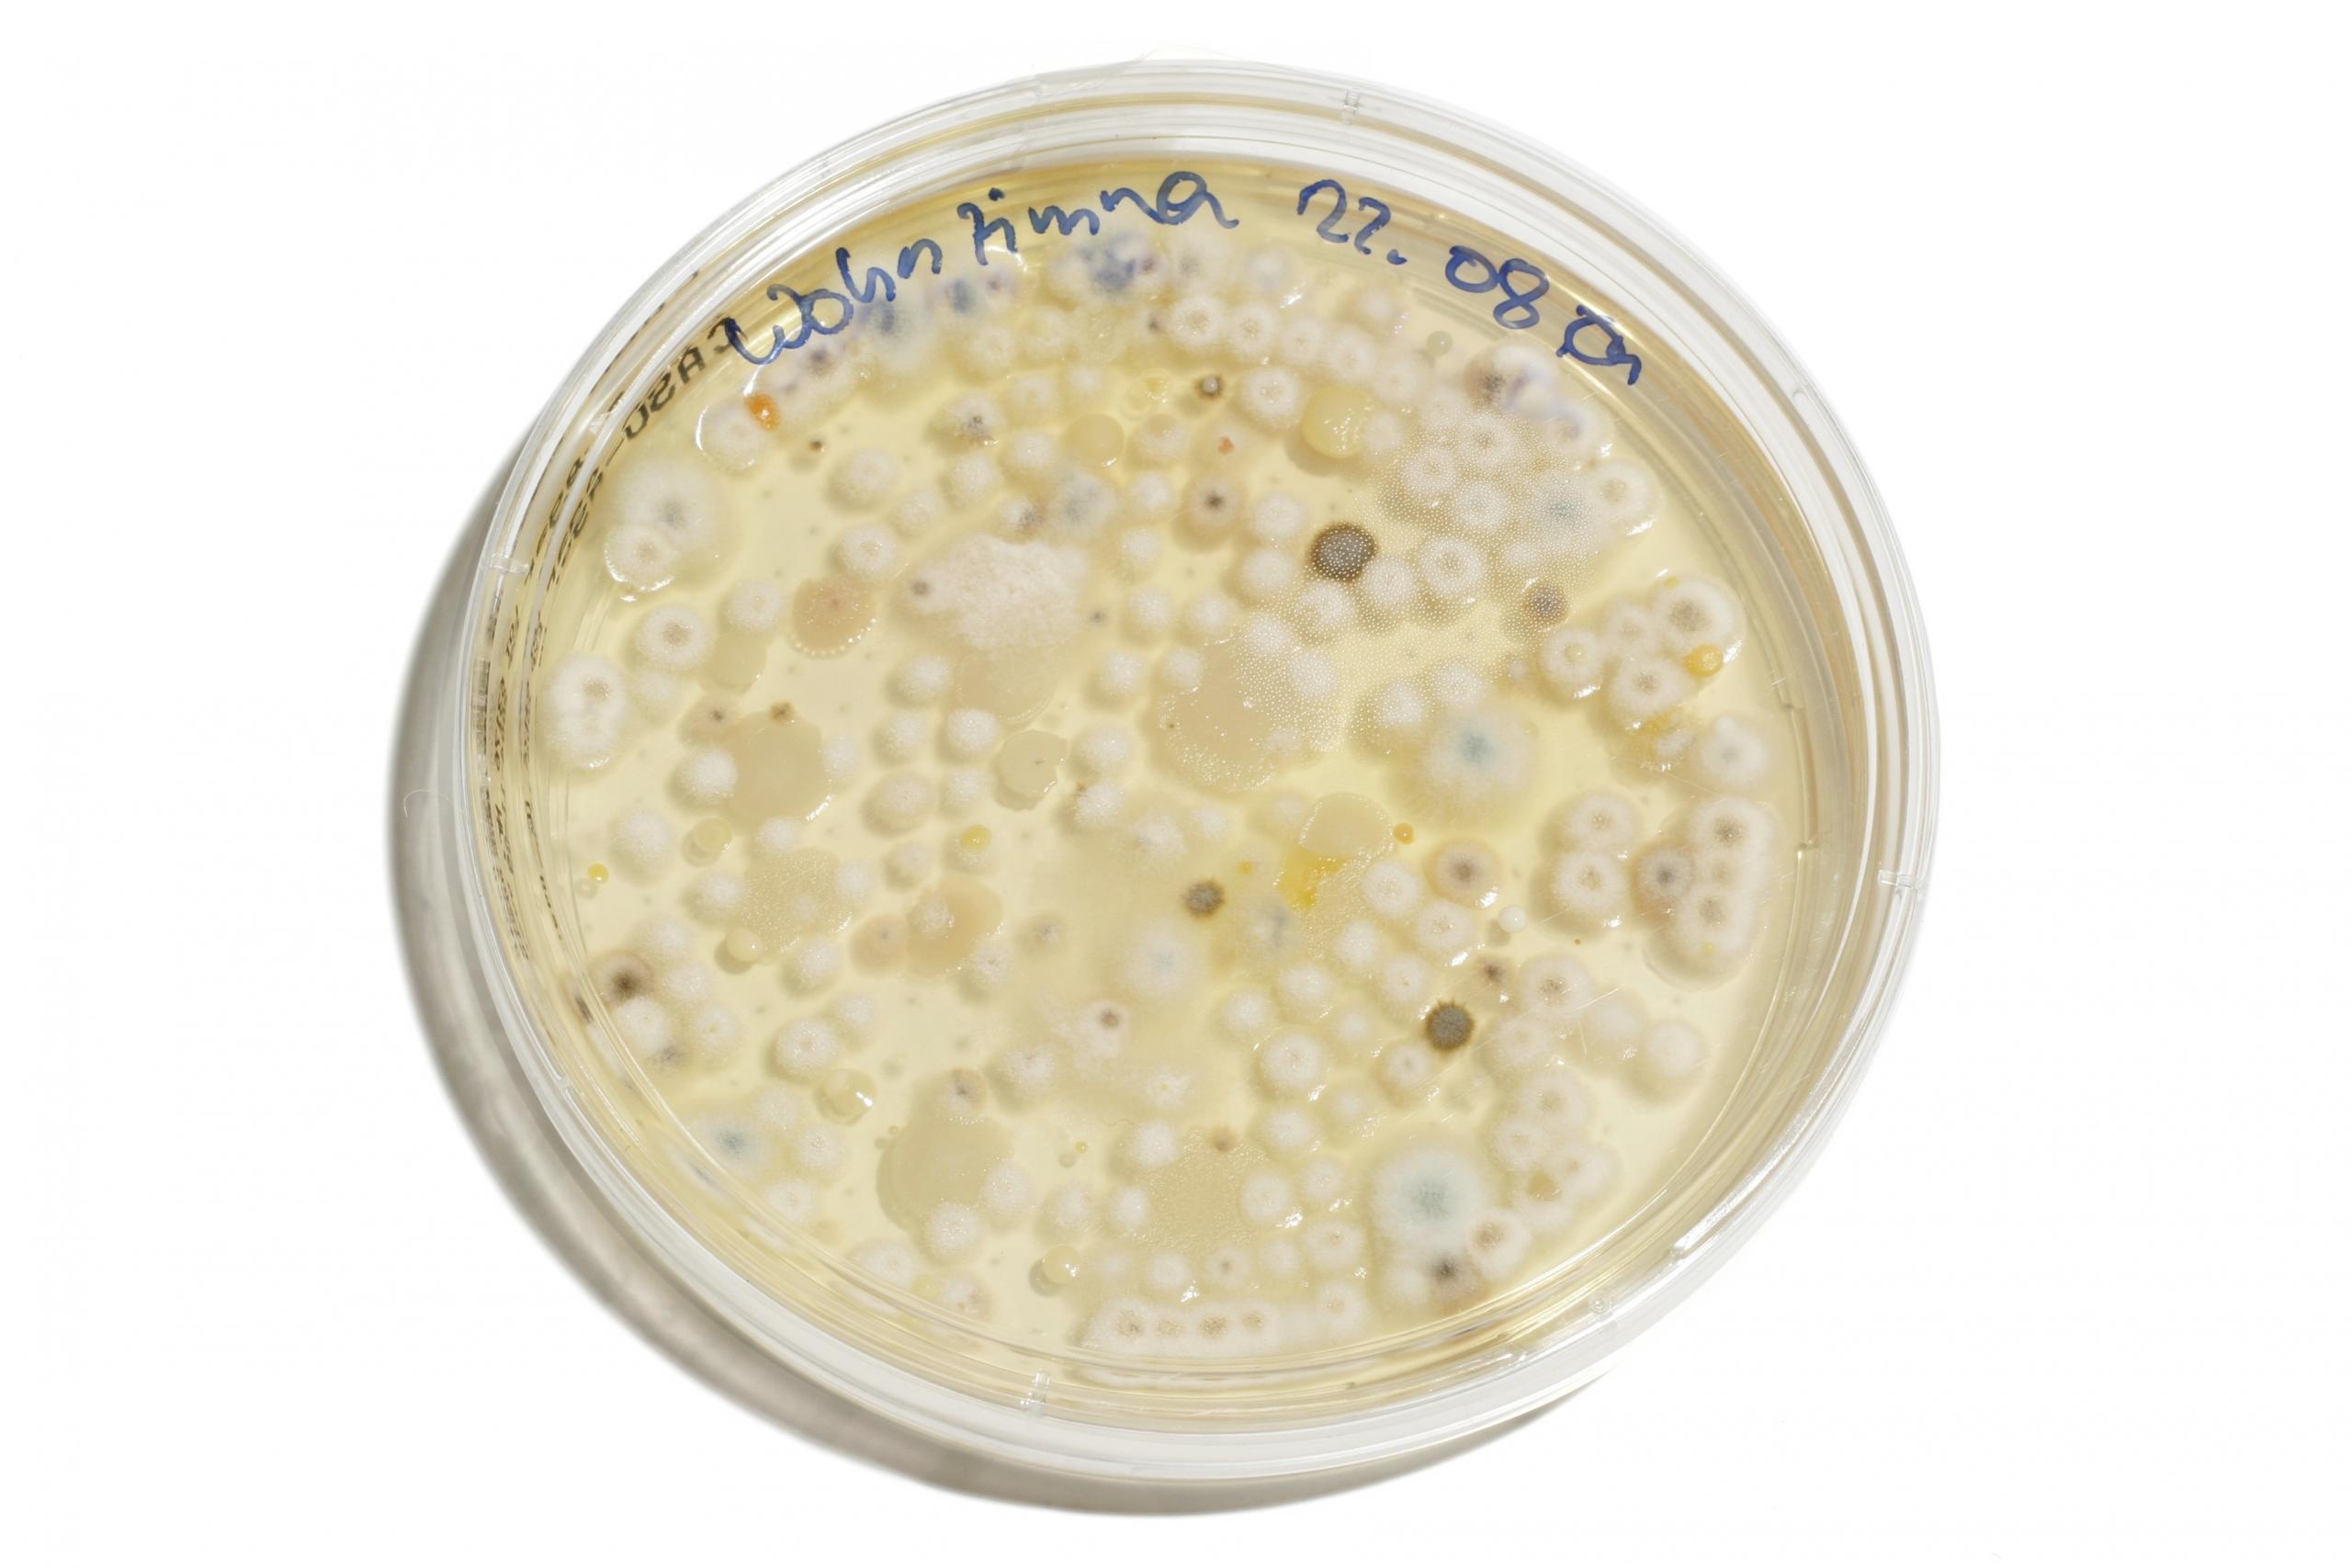
хімічне обладнання

Якщо ви вчений, що знаходиться на старті своєї кар'єри, то, можливо, вже замислювались над створенням особистої лабораторії - місця, де ви могли б експериментувати досхочу. Можливо, відкриття цілої хімічної лабораторії для початку може видатись трохи амбітним заняттям.
Тому спершу можна скористатися науковими наборами, які будь-кому допоможуть відчути себе справжнім вченим-хіміком! Існують набори як для дітей, так і для дорослих.
Але перш ніж піти щось купляти, треба визначитись, що саме ви потребуєте. Пропонуємо вам переглянути список необхідного обладнання, щоб створити у вашому домі куточок для проведення справжніх наукових експериментів!
Хочете більше розумітись не тільки в обладнанні, але й розбиратись в основних хімічних поняттях, переходьте за посиланням!

Базове хімічне обладнання: пробірки й інші ємності
Пробірки
Це найважливіший хімічний посуд, без якого не проведеш жодного хімічного експерименту. Вони мають спеціальну форму та розроблені для того, щоб полегшити вам роботу під час хімічних дослідів. Вони не лускають при нагріванні і не піддаються корозії, якщо наповнювати їх кислотами чи іншими небезпечними елементами. Також їх надзвичайно легко чистити і зберігати. Вони прозорі та зручні для того, щоб спостерігати за хімічними реакціями всередині. Саме тому вчені всього світу обрали пробірки для користування під час своїх дослідів.
Якщо ж ви захотіли придбати пробірки, вам знадобиться й підставка для них. Без неї ваші речовини та розчини швидше за все розіллються на весь стіл. Є також великий вибір пробірок, що ідеально підходять для нагрівання рідини всередині.

Колби
Існує безліч колб, в яких можна змішувати хімічні речовини та спостерігати за цими розчинами. Слід зауважити, що не всі вони необхідні на початку, для перших дослідів. Можна знайти сотні різних спеціальних колб, але стати в нагоді можуть лише деякі з них.
Наприклад, хімічний стакан. Він використовується для вимірювання об'єму рідин, так як оснащений мірними рисками збоку та носиком (або «дзьобом») для наливання.
Конічну колбу – або колбу Ерленмеєра – можна впізнати за її покосими сторонами. Є дві причини, чому форма цього посуду саме така. При розмішуванні розчину така форма зменшує ризик його проливання. Також форма колби робить її ідеальною для кип’ятіння рідин: широка основа та звужені боки дозволяють осідати кондесату на бічних сторонах.
Найважливіші хімічні дослідження точно було зроблено з використанням цього хімічного обладнання!
Бюретка
Бюретка — це вигадлива назва пробірки з краном на кінці. Вона також градуйована, тобто з мірними рисками збоку. Ці дві особливості даного посуду дозволяють виливати з неї розчини в необхідній кількості. Це точно дуже корисний посуд, якщо ви сподіваєтеся вивести свої хімічні експерименти на новий рівень!
Піпетка
Це крихітна пробірка з гумовою насадкою. При стисканні насадки піпетка вбирає рідину. В основному вона використовується для перенесення рідин з однієї пробірки в іншу.
Чашка Петрі
Її часто використовують у біологічній лабораторії для вирощування та вивчення бактерій. Хіміками чашки Петрі нерідко використовуються для вирощування та зберігання кристалів. Скляні трохи краще пластикових, але і ті, й інші підійдуть для домашньої лабораторії!
Про вчених, які зробили найвизначніші дослідження з хімії читайте в нашій статті.
Захисне обладнання для ваших хімічних експериментів
Окуляри та рукавички
Навіть якщо ви підготували всі реагенти, починати досліди можна лише тоді, коли подбаєте про власну безпеку. Окуляри для захисту очей і хімічно стійкі рукавички для ваших рук є абсолютно необхідними.
Деякі речовини, з якими ви будете працювати, можуть бути небезпечними. Кислоти, луги або інші хімікати при потраплянні, наприклад, на шкіру можуть призвести до опіків та й більш серйозних наслідків. Навіть якщо речовини досить безпечні, брати їх голими руками не дуже приємно. Та й хіба у цій всій амуніції не буде цікаво пограти в божевільного ученого?!
Штатив з затискачем
Якщо ви возитеся зі своїми експериментами, не досить зручно буде тримати все у руках. Тому для зручності існують штатив з затискачем. Штатив — це обважнений вертикально поставлений вал зі спеціальним тримачем, куди можна поставити все, щоб звільнити руки від зайвого та з комфортом проводити експерименти.
Наприклад, бюретку. Якщо ви змішуєте один розчин з іншим, одну бюретку закріплюєте на штативі! Це безпечніше, простіше, і кожен справжній науковець користується таким обладнанням.
Важливе додаткове обладнання: це необхідно для розуміння хімічних процесів під час експериментів
Термометр
Отже, що відбувається з вашим експериментом? Занадто гарячий розчин чи ще недостатньо нагрівся? При якій температурі певна хімічна речовина реагує з іншою? При якій температурі вона змінює стан із твердого на рідкий і газоподібний? Як ви виміряєте необхідну температуру без термометра?
Якщо ви прагнете глибше розуміти хімічні процеси,вам обов'язково знадобиться термометр. Хімічні речовини поводяться дуже по-різному при різних температурах, тому краще переконайтеся, що робите все правильно!
А як щодо репетитора з хімії? Він точно допоможе вам зробити все так, щоб будь-яка реакція вдалася!

Лакмусовий папірець
Вже маєте результати перших досліджень в пробірці? А що саме ви отримали?
Лакмусовий папірець - це фундамент для хімічних дослідів. Завдяки йому ви дізнаєтесь, чи є отримане середовище лужним чи кислотним.
Якщо папірець стає червоним - ви отримали кислоту; якщо синім - перед вами луг; якщо колір змінюється на фіолетовий - це нейтральне середовище!
Цікаві факти про кислоти та луги читайте за посиланням.
Періодична таблиця
У кожній хімічній лабораторії кожної школи на стіні можна побачити періодичну таблицю елементів. Без неї неможливо описати, що відбувається у експерименті. Ця таблиця точно розповідає, що собою представляє кожен елемент, який він та з чим може реагувати. Ця вся інформація неймовірно корисна, але лише за умови, якщо ви знаєте, як це читати!
Періодична таблиця впорядкована за атомним номером (також наз. зарядове число). Цей номер показує кількість протонів у ядрі кожного атома та одночасно вказує на його заряд в одиницях елементарного заряду, тобто реакційну здатністю кожного елемента. Цей номер є порядковим для кожного хімічного елементу в таблиці. Таблиця надасть вам інформацію про те, чому фтор і цезій такі реактивні, і допоможе вам зрозуміти, що відбувається, коли реагують два різні елементи. Більше про таблицю Менделєєва читайте в нашій статті.
Репетитор допоможе вам краще розібратися, як читати періодичну таблицю.
Молекулярні моделі
У той час як періодична таблиця може показати вам у числовому виразі, що відбувається в даному атомі, молекулярні моделі пропонують більш практичний спосіб зрозуміти, як утворюються молекули та інші сполуки.
Зазвичай ці моделі виготовлені з пластику. Це конструкції, що містять кульки (котрі символізують атоми) і палички (які символізують хімічні зв’язки). Функція цих моделей в тому, щоб створювати будь-яку молекулу, яку забажаєте, і фактично бачити, що відбувається на хімічному рівні у вашій пробірці.
Ви можете створити молекулярну модель із засобів, що є у вас під рукою. Просто візьміть кілька різнокольорових кульок і, наприклад, соломинок, та створіть усі молекули, які тільки можете собі уявити!
Пальник Бунзена
Чесно кажучи, це, ймовірно, не те, що знадобиться в домашній лабораторії. Хоча чому б не помріяти?!
Пальник Бунзена — це інструмент, який продукує дуже чисте та чітке полум’я з газу. Він надзвичайно корисний для нагрівання розчинів, спалювання елементів для окислення та спостереження за реакцією речовин на тепло.
Однак проблема полягає в тому, що його треба під’єднати до газової мережі. Якщо ви дитина, ваші батьки можуть не довірити вам це зробити (хоча, якщо ви дорослий, ваші сусіди також можуть бути не раді таким експериментам). Тому паяльник трохи складно встановити вдома.
Якщо ж ви рішуче налаштовані, тоді вперед! Безліч наукових експериментів не обійдеться без паяльника Бунзена!
Штатив-тринога і марля
Якщо ви використовуєте паяльник Бунзена, то повинні розуміти одну досить просту річ: предмет стає дуже гарячим, коли ви ставите його на вогонь! Тому iснують штатив-тринога і марля: штатив акуратно ставиться над пальником Бунзена. А вже на нього можна поставити ємність, в якій нагріватиметься речовина, наприклад, конічну колбу. Таким чином, вам не потрібно буде тримати розжарену колбу в руках. Марлю кладуть під колбу і вона розподіляє тепло, отже ваш розчин прогріватиметься рівномірно.
Хочете дізнатись ще більше? Про основне з хімії читайте в нашій статті!
Підсумувати за допомогою ШІ:















